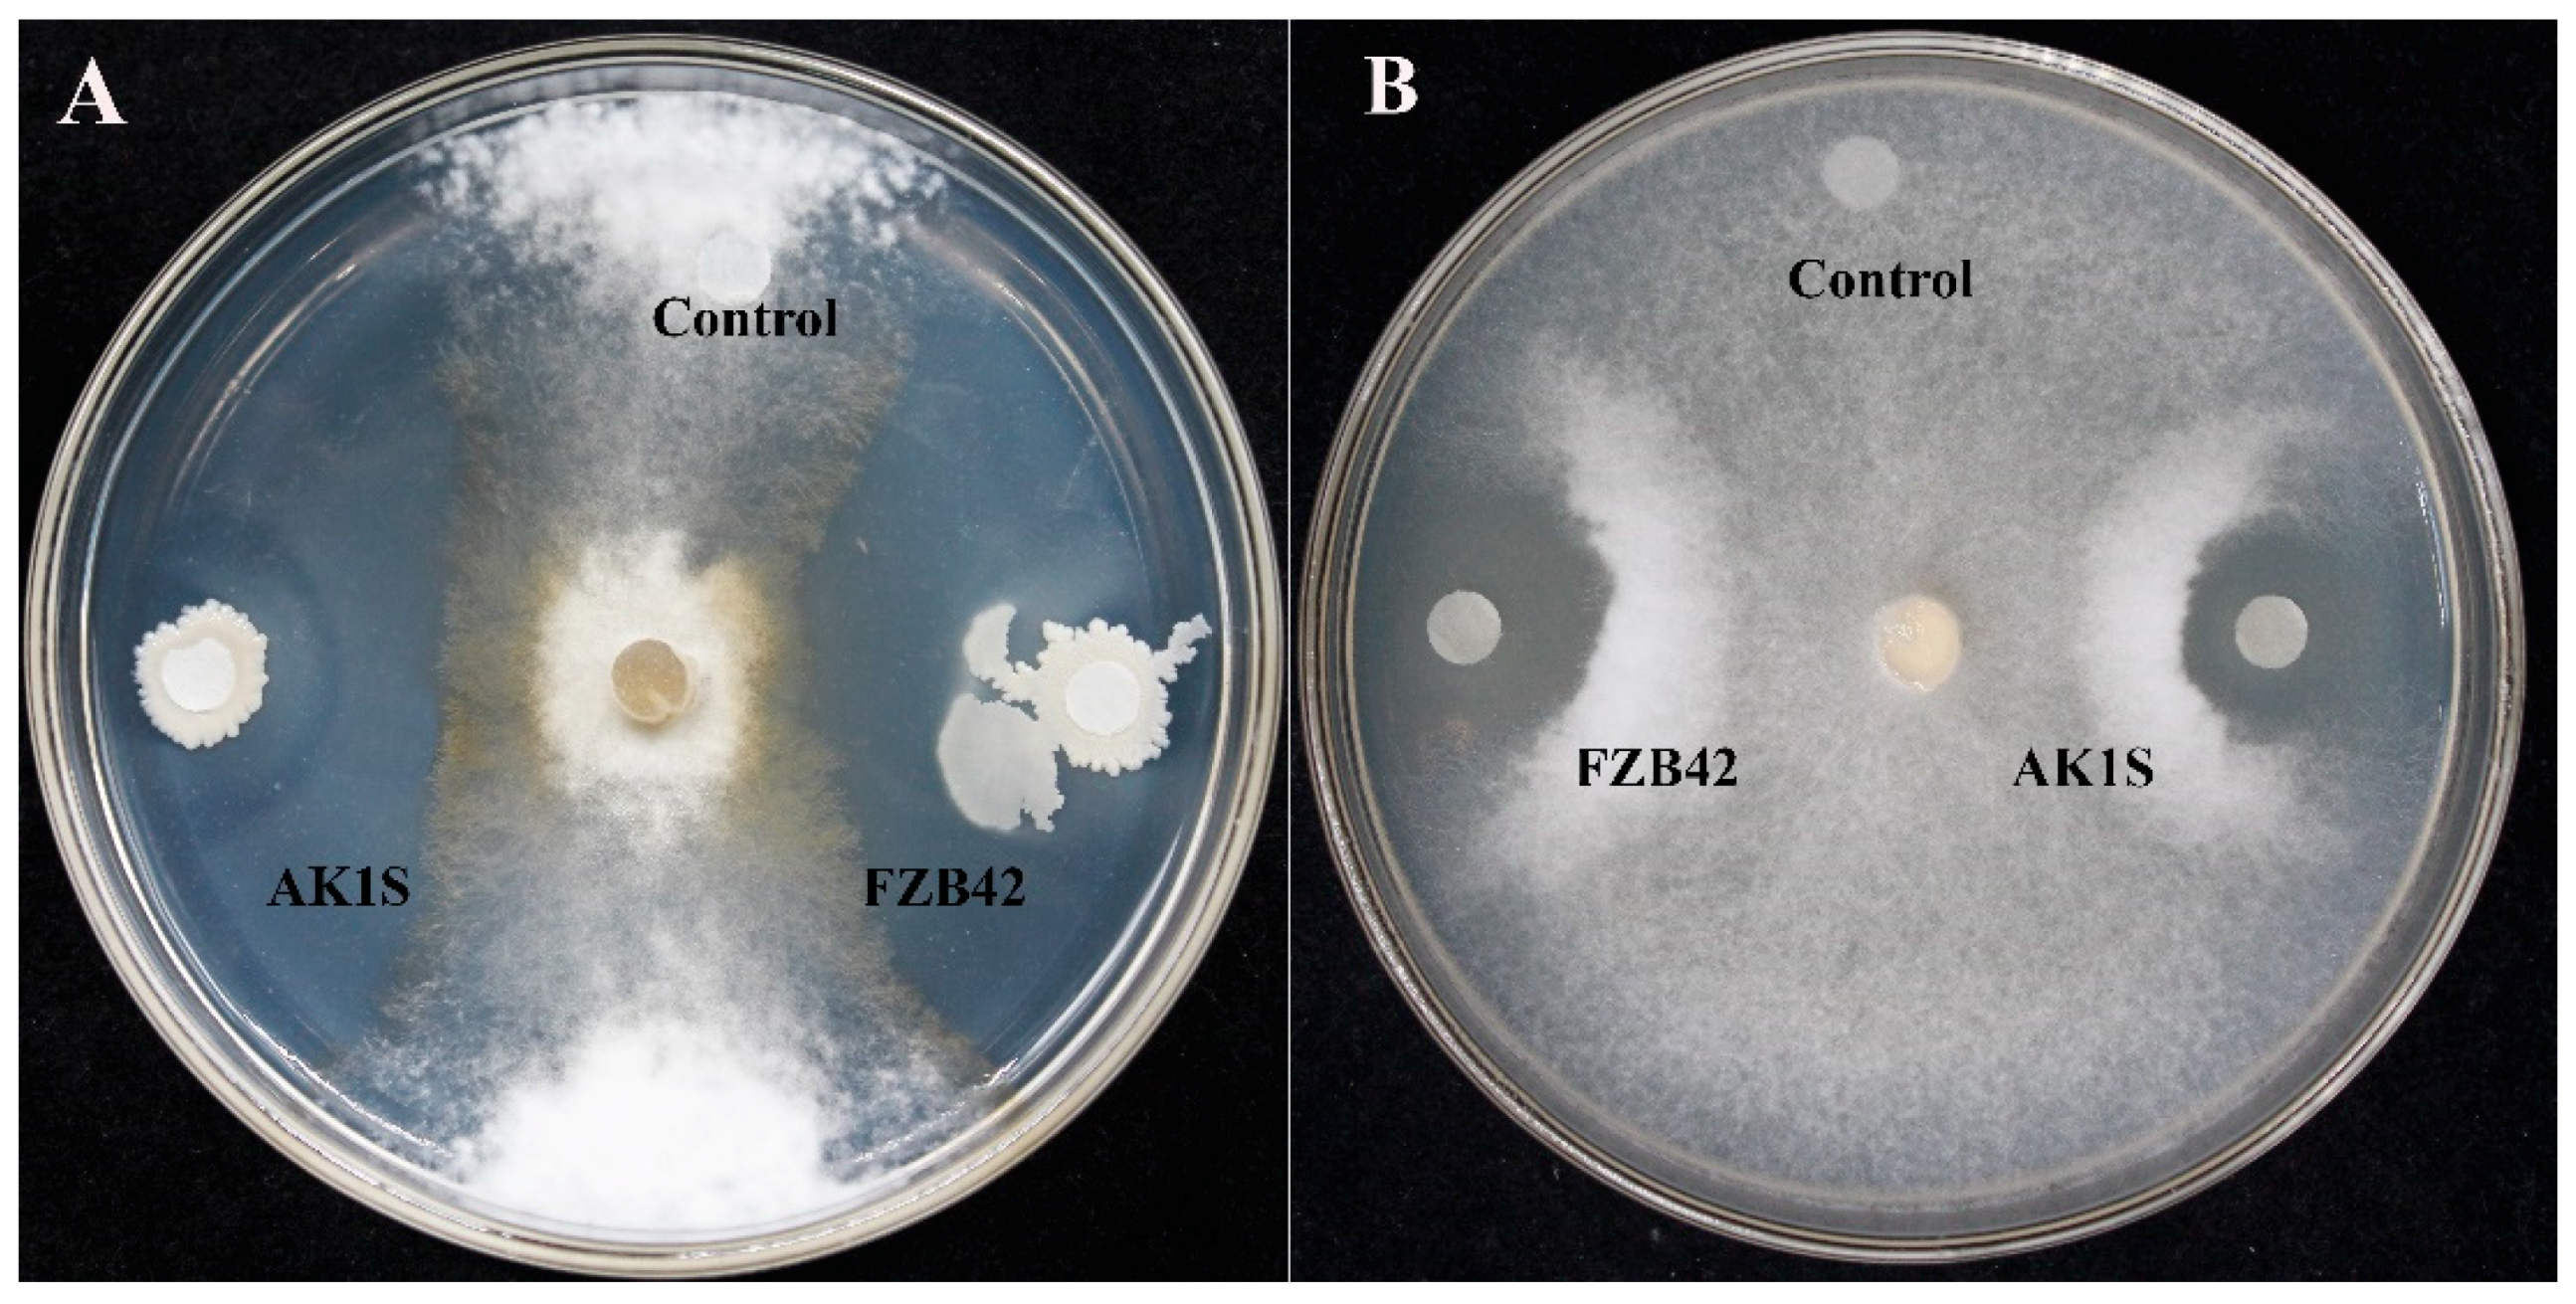
Biomolecules 09 00613 g001 Biomolecules 09 00613 g001

Suppression of Sclerotinia sclerotiorum by the Induction of Systemic Resistance and Regulation of Antioxidant Pathways in Tomato Using Fengycin Produced by Bacillus amyloliquefaciens FZB42
Abstract
1. Introduction
2. Materials and Methods
2.1. Bacterial and Fungal Cultures
2.2. Antifungal Activity Assay
2.3. Extraction and Purification of Fengycin from B. Amyloliquefaciens FZB42 Mutant AK1S
2.4. Ultrastructural Changes in the Fungal Mycelium
2.5. Assessment of Reactive Oxygen Species
2.6. Induction of ISR in Tomato Plants by Fengycin
2.7. Extraction of Total RNA and Expression Analysis by RT-qPCR
2.8. Statistical Analysis
3. Results
3.1. Antifungal Activity Assay
3.2. HPLC- and MALDI-TOF-MS-Based Detection of Fengycin
3.3. Fengycin Induced Ultrastructural Changes in S. sclerotiorum Hyphae
3.4. ROS Accumulation in S. sclerotiorum Hyphae
3.5. Expression of ROS-Scavenging Genes in S. sclerotiorum
3.6. Induction of ISR in Tomato Plants by Fengycin
3.7. RT-qPCR Analysis of Defense-Related Genes in Tomato
4. Discussion
5. Conclusions
Author Contributions
Funding
Conflicts of Interest
References
- Chen, X.H.; Koumoutsi, A.; Scholz, R.; Eisenreich, A.; Schneider, K.; Heinemeyer, I.; Morgenstern, B.; Voss, B.; Hess, W.R.; Reva, O.; et al. Comparative analysis of the complete genome sequence of the plant growth–promoting bacterium Bacillus amyloliquefaciens FZB42. Nat. Biotechnol. 2007, 25, 1007–1014. [Google Scholar] [CrossRef] [PubMed]
- Whipps, J.M.; Sreenivasaprasad, S.; Muthumeenakshi, S.; Rogers, C.W.; Challen, M.P. Use of Coniothyrium minitansas a biocontrol agent and some molecular aspects of sclerotial mycoparasitism. Eur. J. Plant Pathol. 2008, 121, 323–330. [Google Scholar] [CrossRef]
- Shafi, J.; Tian, H.; Ji, M. Bacillus species as versatile weapons for plant pathogens: A review. Biotechnol. Biotechnol. Equip. 2017, 31, 446–459. [Google Scholar] [CrossRef]
- Compants, S. Use of plant growth-promoting bacteria for biocontrol of plant diseases: Principles, mechanisms of action, and future prospects. Appl. Environ. Microbiol. 2005, 71, 4951–4959. [Google Scholar] [CrossRef] [PubMed]
- Ongena, M.; Jacques, P.; Touré, Y.; Destain, J.; Jabrane, A.; Thonart, P. Involvement of fengycin-type lipopeptides in the multifaceted biocontrol potential of Bacillus subtilis. Appl. Microbiol. Biotechnol. 2005, 69, 29–38. [Google Scholar] [CrossRef]
- Ongena, M.; Jacques, P. Bacillus lipopeptides: versatile weapons for plant disease biocontrol. Trends Microbiol. 2008, 16, 115–125. [Google Scholar] [CrossRef]
- Koumoutsi, A.; Chen, X.-H.; Vater, J.; Borriss, R. DegU and YczE Positively Regulate the Synthesis of Bacillomycin D by Bacillus amyloliquefaciens Strain FZB42. Appl. Environ. Microbiol. 2007, 73, 6953–6964. [Google Scholar] [CrossRef]
- Bulgarelli, D.; Schlaeppi, K.; Spaepen, S.; van Themaat, E.V.L.; Schulze-Lefert, P. Structure and Functions of the Bacterial Microbiota of Plants. Annu. Rev. Plant Biol. 2012, 64, 807–838. [Google Scholar] [CrossRef]
- Moyne, A.-L.; Cleveland, T.E.; Tuzun, S. Molecular characterization and analysis of the operon encoding the antifungal lipopeptide bacillomycin D. FEMS Microbiol. Lett. 2004, 234, 43–49. [Google Scholar] [CrossRef]
- Lee, D.W.; Kim, B.S. Antimicrobial Cyclic Peptides for Plant Disease Control. Plant Pathol. J. 2015, 31, 1–11. [Google Scholar] [CrossRef]
- Hanif, A.; Zhang, F.; Li, P.; Li, C.; Xu, Y.; Zubair, M.; Zhang, M.; Jia, D.; Zhao, X.; Liang, J.; et al. Fengycin Produced by Bacillus amyloliquefaciens FZB42 Inhibits Fusarium graminearum Growth and Mycotoxins Biosynthesis. Toxins 2019, 11, 295. [Google Scholar] [CrossRef] [PubMed]
- Nishikiori, T. Plipastatins: New inhibitors of phospholipase A2 produced by Bacillus cereus BMG302-fF67, III. Structural elucidation of plipastatins. J. Antibiot. 1986, 39, 737. [Google Scholar] [CrossRef] [PubMed]
- Deleu, M.; Paquot, M.; Nylander, T. Effect of Fengycin, a Lipopeptide Produced by Bacillus subtilis, on Model Biomembranes. Biophys. J. 2008, 94, 2667–2679. [Google Scholar] [CrossRef] [PubMed]
- Yamamoto, S.; Shiraishi, S.; Kawagoe, Y.; Mai, M.; Suzuki, S. Impact of Bacillus amyloliquefaciens S13 -3 on control of bacterial wilt and powdery mildew in tomato. Pest. Manag. Sci. 2015, 71, 722–727. [Google Scholar] [CrossRef]
- Lin, F.; Xue, Y.; Huang, Z.; Jiang, M.; Lu, F.; Bie, X.; Miao, S.; Lu, Z. Bacillomycin D inhibits growth of Rhizopus stolonifer and induces defense-related mechanism in cherry tomato. Appl. Microbiol. Biotechnol. 2019, 103, 7663–7674. [Google Scholar] [CrossRef]
- Bakker, P.A.H.M.; Pieterse, C.M.J.; Van Loon, L.C. SYSTEMIC RESISTANCE INDUCED BY RHIZOSPHERE BACTERIA. Annu. Rev. Phytopathol. 1998, 36, 453–483. [Google Scholar]
- Ahuja, I.; Kissen, R.; Bones, A.M. Phytoalexins in defense against pathogens. Trends Plant Sci. 2012, 17, 73–90. [Google Scholar] [CrossRef]
- Moosa, A.; Farzand, A.; Sahi, S.T.; Khan, S.A. Transgenic expression of antifungal pathogenesis-related proteins against phytopathogenic fungi – 15 years of success. Isr. J. Plant Sci. 2017, 32, 1–17. [Google Scholar] [CrossRef]
- Li, L.; Steffens, J. Overexpression of polyphenol oxidase in transgenic tomato plants results in enhanced bacterial disease resistance. Planta 2002, 215, 239–247. [Google Scholar] [CrossRef]
- Van Loon, L.; Rep, M.; Pieterse, C. Significance of Inducible Defense-related Proteins in Infected Plants. Annu. Rev. Phytopathol. 2006, 44, 135–162. [Google Scholar] [CrossRef]
- Sharma, P.; Jha, A.B.; Dubey, R.S.; Pessarakli, M. Reactive Oxygen Species, Oxidative Damage, and Antioxidative Defense Mechanism in Plants under Stressful Conditions. J. Bot. 2012, 2012, 1–26. [Google Scholar] [CrossRef]
- Raaijmakers, J.M.; De Bruijn, I.; Nybroe, O.; Ongena, M. Natural functions of lipopeptides from Bacillus and Pseudomonas: More than surfactants and antibiotics. FEMS Microbiol. Rev. 2010, 34, 1037–1062. [Google Scholar] [CrossRef] [PubMed]
- Ongena, M.; Jourdan, E.; Adam, A.; Paquot, M.; Brans, A.; Joris, B.; Arpigny, J.-L.; Thonart, P. Surfactin and fengycin lipopeptides of Bacillus subtilis as elicitors of induced systemic resistance in plants. Environ. Microbiol. 2007, 9, 1084–1090. [Google Scholar] [CrossRef] [PubMed]
- Waewthongrak, W.; Leelasuphakul, W.; Mccollum, G. Cyclic Lipopeptides from Bacillus subtilis ABS–S14 Elicit Defense-Related Gene Expression in Citrus Fruit. PLoS ONE 2014, 9, e109386. [Google Scholar] [CrossRef] [PubMed]
- Yamamoto, S.; Shiraishi, S.; Suzuki, S. Are cyclic lipopeptides produced by Bacillus amyloliquefaciens S13-3 responsible for the plant defence response in strawberry against Colletotrichum gloeosporioides? Lett. Appl. Microbiol. 2015, 60, 379–386. [Google Scholar] [CrossRef] [PubMed]
- Chandler, S.; Van Hese, N.; Coutte, F.; Jacques, P.; Höfte, M.; De Vleesschauwer, D. Role of cyclic lipopeptides produced by Bacillus subtilis in mounting induced immunity in rice (Oryza sativa L.). Physiol. Mol. Plant Pathol. 2015, 91, 20–30. [Google Scholar] [CrossRef]
- Hussein, W.; Awad, H.; Fahim, S. Systemic resistance induction of tomato plants against ToMV virus by surfactin produced from Bacillus subtilis BMG02. Am. J. Microbiol. Res. 2016, 4, 153–158. [Google Scholar]
- Zhang, L.; Sun, C. Fengycins, Cyclic Lipopeptides from Marine Bacillus subtilis Strains, Kill the Plant-Pathogenic Fungus Magnaporthe grisea by Inducing Reactive Oxygen Species Production and Chromatin Condensation. Appl. Environ. Microbiol. 2018, 84, e00445-18. [Google Scholar] [CrossRef]
- Schneider, J.; Taraz, K.; Budzikiewicz, H.; Deleu, M.; Thonart, P.; Jacques, P. The Structure of Two Fengycins from Bacillus subtilis S499. Zeitschrift für Naturforschung C 1999, 54, 859–866. [Google Scholar] [CrossRef]
- Steller, S.; Vollenbroich, D.; Leenders, F.; Stein, T.; Conrad, B.; Hofemeister, J.; Jacques, P.; Thonart, P.; Vater, J. Structural and functional organization of the fengycin synthetase multienzyme system from Bacillus subtilis b213 and A1/3. Chem. Boil. 1999, 6, 31–41. [Google Scholar] [CrossRef]
- Koumoutsi, A.; Chen, X.-H.; Henne, A.; Liesegang, H.; Hitzeroth, G.; Franke, P.; Vater, J.; Borriss, R. Structural and Functional Characterization of Gene Clusters Directing Nonribosomal Synthesis of Bioactive Cyclic Lipopeptides in Bacillus amyloliquefaciens Strain FZB42. J. Bacteriol. 2004, 186, 1084–1096. [Google Scholar] [CrossRef] [PubMed]
- Zhang, S.-M. Isolation and characterization of antifungal lipopeptides produced by endophytic Bacillus amyloliquefaciens TF28. Afr. J. Microbiol. Res. 2012, 6, 1747–1755. [Google Scholar]
- Chen, H.; Wang, L.; Su, C.; Gong, G.; Wang, P.; Yu, Z. Isolation and characterization of lipopeptide antibiotics produced by Bacillus subtilis. Lett. Appl. Microbiol. 2008, 47, 180–186. [Google Scholar] [CrossRef] [PubMed]
- Vater, J.; Gao, X.; Hitzeroth, G.; Wilde, C.; Franke, P. “Whole cell”--matrix-assisted laser desorption ionization-time of flight-mass spectrometry, an emerging technique for efficient screening of biocombinatorial libraries of natural compounds-present state of research. Comb. Chem. High Throughput Screen. 2003, 6, 557–567. [Google Scholar] [CrossRef]
- Stein, T. Bacillus subtilis antibiotics: structures, syntheses and specific functions. Mol. Microbiol. 2005, 56, 845–857. [Google Scholar] [CrossRef]
- Chen, X.; Koumoutsi, A.; Scholz, R.; Schneider, K.; Vater, J.; Süssmuth, R.; Piel, J.; Borriss, R. Genome analysis of Bacillus amyloliquefaciens FZB42 reveals its potential for biocontrol of plant pathogens. J. Biotechnol. 2009, 140, 27–37. [Google Scholar] [CrossRef]
- Farzand, A.; Moosa, A.; Zubair, M.; Khan, A.R.; Hanif, A.; Tahir, H.A.S.; Gao, X. Marker assisted detection and LC-MS analysis of antimicrobial compounds in different Bacillus strains and their antifungal effect on Sclerotinia sclerotiorum. Boil. Control. 2019, 133, 91–102. [Google Scholar] [CrossRef]
- Farzand, A.; Moosa, A.; Zubair, M.; Khan, A.R.; Ayaz, M.; Massawe, V.C.; Gao, X. Transcriptional profiling of diffusible lipopeptides and fungal virulence genes during Bacillus amyloliquefaciens EZ1509 mediated suppression of Sclerotinia sclerotiorum. Phytopathology 2019. [Google Scholar] [CrossRef]
- Kumar, P.; Dubey, R.; Maheshwari, D.; Dubey, R. Bacillus strains isolated from rhizosphere showed plant growth promoting and antagonistic activity against phytopathogens. Microbiol. Res. 2012, 167, 493–499. [Google Scholar] [CrossRef]
- Cawoy, H.; Debois, D.; Franzil, L.; De Pauw, E.; Thonart, P.; Ongena, M. Lipopeptides as main ingredients for inhibition of fungal phytopathogens by Bacillus subtilis/amyloliquefaciens. Microb. Biotechnol. 2015, 8, 281–295. [Google Scholar] [CrossRef]
- Romero, D.; De Vicente, A.; Rakotoaly, R.H.; Dufour, S.E.; Veening, J.-W.; Arrebola, E.; Cazorla, F.M.; Kuipers, O.P.; Paquot, M.; Perez-Garcia, A. The Iturin and Fengycin Families of Lipopeptides Are Key Factors in Antagonism of Bacillus subtilis Toward Podosphaera fusca. Mol. Plant-Microbe Interactions 2007, 20, 430–440. [Google Scholar] [CrossRef]
- Touré, Y.; Ongena, M.; Jacques, P.; Guiro, A.; Thonart, P. Role of lipopeptides produced by Bacillus subtilis GA1 in the reduction of grey mould disease caused by Botrytis cinerea on apple. J. Appl. Microbiol. 2004, 96, 1151–1160. [Google Scholar] [CrossRef] [PubMed]
- Yang, H.; Li, X.; Li, X.; Yu, H.; Shen, Z. Identification of lipopeptide isoforms by MALDI-TOF-MS/MS based on the simultaneous purification of iturin, fengycin, and surfactin by RP-HPLC. Anal. Bioanal. Chem. 2015, 407, 2529–2542. [Google Scholar] [CrossRef]
- Kim, P.I.; Ryu, J.; Kim, Y.H.; Chi, Y.-T. Production of biosurfactant lipopeptides Iturin A, fengycin and surfactin A from Bacillus subtilis CMB32 for control of Colletotrichum gloeosporioides. J. Microbiol. Biotechnol. 2010, 20, 138–145. [Google Scholar] [PubMed]
- Vater, J.; Kablitz, B.; Wilde, C.; Franke, P.; Mehta, N.; Cameotra, S.S. Matrix-Assisted Laser Desorption Ionization-Time of Flight Mass Spectrometry of Lipopeptide Biosurfactants in Whole Cells and Culture Filtrates of Bacillus subtilis C-1 Isolated from Petroleum Sludge. Appl. Environ. Microbiol. 2002, 68, 6210–6219. [Google Scholar] [CrossRef]
- Athukorala, S.N.; Rashid, K.Y.; Fernando, W.G.D. Identification of antifungal antibiotics of Bacillus species isolated from different microhabitats using polymerase chain reaction and MALDI-TOF mass spectrometry. Can. J. Microbiol. 2009, 55, 1021–1032. [Google Scholar] [CrossRef] [PubMed]
- Bonmatin, J.-M.; Laprévote, O.; Peypoux, F. Diversity among microbial cyclic lipopeptides: iturins and surfactins. Activity-structure relationships to design new bioactive agents. Comb. Chem. High Throughput Screen. 2003, 6, 541–556. [Google Scholar] [CrossRef]
- Sun, L.; Lu, Z.; Bie, X.; Lu, F.; Yang, S. Isolation and characterization of a co-producer of fengycins and surfactins, endophytic Bacillus amyloliquefaciens ES-2, from Scutellaria baicalensis Georgi. World J. Microbiol. Biotechnol. 2006, 22, 1259–1266. [Google Scholar] [CrossRef]
- Escobar, V.V.; Ceballos, I.; Mira, J.J.; Argel, L.E.; Peralta, S.O.; Romero-Tabarez, M. Fengycin C Produced by Bacillus subtilis EA-CB0015. J. Nat. Prod. 2013, 76, 503–509. [Google Scholar] [CrossRef]
- Brogden, A.K. Antimicrobial peptides: Pore formers or metabolic inhibitors in bacteria? Nat. Rev. Microbiol. 2005, 3, 238–250. [Google Scholar] [CrossRef]
- Sajitha, K.; Dev, S.A. Quantification of antifungal lipopeptide gene expression levels in Bacillus subtilis B1 during antagonism against sapstain fungus on rubberwood. Boil. Control. 2016, 96, 78–85. [Google Scholar] [CrossRef]
- Tao, Y.; Bie, X.-M.; Lv, F.-X.; Zhao, H.-Z.; Lu, Z.-X. Antifungal activity and mechanism of fengycin in the presence and absence of commercial surfactin against Rhizopus stolonifer. J. Microbiol. 2011, 49, 146–150. [Google Scholar] [CrossRef] [PubMed]
- Liu, J.; Zhou, T.; He, D.; Li, X.-Z.; Wu, H.; Liu, W.; Gao, X. Functions of Lipopeptides Bacillomycin D and Fengycin in Antagonism of Bacillus amyloliquefaciens C06 towards Monilinia fructicola. J. Mol. Microbiol. Biotechnol. 2011, 20, 43–52. [Google Scholar] [CrossRef] [PubMed]
- Deleu, M.; Paquot, M.; Nylander, T. Fengycin interaction with lipid monolayers at the air–aqueous interface—implications for the effect of fengycin on biological membranes. J. Colloid Interface Sci. 2005, 283, 358–365. [Google Scholar] [CrossRef] [PubMed]
- Cadenas, E.; Davies, K.J. Mitochondrial free radical generation, oxidative stress, and aging. Free. Radic. Boil. Med. 2000, 29, 222–230. [Google Scholar] [CrossRef]
- Tang, Q.; Bie, X.; Lu, Z.; Lv, F.; Tao, Y.; Qu, X. Effects of fengycin from Bacillus subtilis fmbJ on apoptosis and necrosis in Rhizopus stolonifer. J. Microbiol. 2014, 52, 675–680. [Google Scholar] [CrossRef] [PubMed]
- Han, Q.; Wu, F.; Wang, X.; Qi, H.; Shi, L.; Ren, A.; Liu, Q.; Zhao, M.; Tang, C. The bacterial lipopeptide iturins induce Verticillium dahliae cell death by affecting fungal signalling pathways and mediate plant defence responses involved in pathogen-associated molecular pattern-triggered immunity. Environ. Microbiol. 2015, 17, 1166–1188. [Google Scholar] [CrossRef] [PubMed]
- Gu, Q.; Yang, Y.; Yuan, Q.; Shi, G.; Wu, L.; Lou, Z.; Huo, R.; Wu, H.; Borriss, R.; Gao, X. Bacillomycin D produced by Bacillus amyloliquefaciens is involved in the antagonistic interaction with the plant pathogenic fungus Fusarium graminearum. Appl. Environ. Microbiol. 2017, 83, e01075-17. [Google Scholar] [CrossRef]
- Heil, M.; Bostock, R.M. Induced Systemic Resistance (ISR) Against Pathogens in the Context of Induced Plant Defences. Ann. Bot. 2002, 89, 503–512. [Google Scholar] [CrossRef]
- De León, I.P.; Montesano, M. Activation of Defense Mechanisms against Pathogens in Mosses and Flowering Plants. Int. J. Mol. Sci. 2013, 14, 3178–3200. [Google Scholar] [CrossRef]
- Bolouri Moghaddam, M.R.; Vilcinskas, A.; Rahnamaeian, M. Cooperative interaction of antimicrobial peptides with the interrelated immune pathways in plants. Mol. Plant Pathol. 2016, 17, 464–471. [Google Scholar] [CrossRef] [PubMed]
- Alscher, R.G.; Erturk, N.; Heath, L.S. Role of superoxide dismutases (SODs) in controlling oxidative stress in plants. J. Exp. Bot. 2002, 53, 1331–1341. [Google Scholar] [CrossRef] [PubMed]
- Vilanova, L.; Viñas, I.; Torres, R.; Usall, J.; Buron-Moles, G.; Teixidó, N. Increasing maturity reduces wound response and lignification processes against Penicillium expansum (pathogen) and Penicillium digitatum (non-host pathogen) infection in apples. Postharvest Boil. Technol. 2014, 88, 54–60. [Google Scholar] [CrossRef]
- Zhang, Y.; Zeng, L.; Yang, J.; Zheng, X.; Yu, T. 6-Benzylaminopurine inhibits growth of Monilinia fructicola and induces defense-related mechanism in peach fruit. Food Chem. 2015, 187, 210–217. [Google Scholar] [CrossRef] [PubMed]
- Li, Y.; Gu, Y.; Li, J.; Xu, M.; Wei, Q.; Wang, Y. Biocontrol agent Bacillus amyloliquefaciens LJ02 induces systemic resistance against cucurbits powdery mildew. Front. Microbiol. 2015, 6, 883. [Google Scholar] [CrossRef] [PubMed]
- Sharma, P.; Dubey, R.S. Drought Induces Oxidative Stress and Enhances the Activities of Antioxidant Enzymes in Growing Rice Seedlings. Plant Growth Regul. 2005, 46, 209–221. [Google Scholar] [CrossRef]
- Chandra, A.; Saxena, R.; Dubey, A.; Saxena, P. Change in phenylalanine ammonia lyase activity and isozyme patterns of polyphenol oxidase and peroxidase by salicylic acid leading to enhance resistance in cowpea against Rhizoctonia solani. Acta Physiol. Plant. 2007, 29, 361–367. [Google Scholar] [CrossRef]
- Prathuangwong, S.; Buensanteai, N. Bacillus amyloliquefaciens induced systemic resistance against bacterial pustule pathogen with increased phenols, phenylalanine ammonia lyase, peroxidases and 1, 3-β-glucanases in soybean plants. Acta Phytopathol. et Entomol. Hung. 2007, 42, 321–330. [Google Scholar] [CrossRef]
- Li, S.-B.; Fang, M.; Zhou, R.-C.; Huang, J. Characterization and evaluation of the endophyte Bacillus B014 as a potential biocontrol agent for the control of Xanthomonas axonopodis pv. dieffenbachiae—Induced blight of Anthurium. Boil. Control. 2012, 63, 9–16. [Google Scholar]
- Li, Y.; Héloir, M.C.; Zhang, X.; Geissler, M.; Trouvelot, S.; Jacquens, L.; Henkel, M.; Su, X.; Fang, X.; Wang, Q. Surfactin and fengycin contribute to the protection of a Bacillus subtilis strain against grape downy mildew by both direct effect and defence stimulation. Mol. Plant Pathol. 2019, 20, 1037–1050. [Google Scholar] [CrossRef]
- Pitzschke, A.; Schikora, A.; Hirt, H. MAPK cascade signalling networks in plant defence. Curr. Opin. Plant Boil. 2009, 12, 421–426. [Google Scholar] [CrossRef] [PubMed]
- Lu, K.; Guo, W.; Lu, J.; Yu, H.; Qu, C.; Tang, Z.; Li, J.; Chai, Y.; Liang, Y. Genome-Wide Survey and Expression Profile Analysis of the Mitogen-Activated Protein Kinase (MAPK) Gene Family in Brassica rapa. PLoS ONE 2015, 10, e0132051. [Google Scholar]
- Beckers, G.J.; Jaskiewicz, M.; Liu, Y.; Underwood, W.R.; He, S.Y.; Zhang, S.; Conrath, U. Mitogen-Activated Protein Kinases 3 and 6 Are Required for Full Priming of Stress Responses in Arabidopsis thaliana[W][OA]. Plant Cell 2009, 21, 944–953. [Google Scholar] [CrossRef] [PubMed]
- Nianiou-Obeidat, I.; Madesis, P.; Kissoudis, C.; Voulgari, G.; Chronopoulou, E.; Tsaftaris, A.; Labrou, N.E. Plant glutathione transferase-mediated stress tolerance: functions and biotechnological applications. Plant Cell Rep. 2017, 36, 791–805. [Google Scholar] [CrossRef]
- Dalton, D.A.; Boniface, C.; Turner, Z.; Lindahl, A.; Kim, H.J.; Jelinek, L.; Govindarajulu, M.; Finger, R.E.; Taylor, C.G. Physiological Roles of Glutathione S-Transferases in Soybean Root Nodules1. Plant Physiol. 2009, 150, 521–530. [Google Scholar] [CrossRef]
- Sharma, R.; Sahoo, A.; Devendran, R.; Jain, M. Over-Expression of a Rice Tau Class Glutathione S-Transferase Gene Improves Tolerance to Salinity and Oxidative Stresses in Arabidopsis. PLoS ONE 2014, 9, e92900. [Google Scholar] [CrossRef]
- Chappell, J. Biochemistry and Molecular Biology of the Isoprenoid Biosynthetic Pathway in Plants. Annu. Rev. Plant Boil. 1995, 46, 521–547. [Google Scholar] [CrossRef]
- Rodríguez-Concepción, M.; Campos, N.; Ferrer, A.; Boronat, A. Biosynthesis of Isoprenoid Precursors in Arabidopsis. In Isoprenoid Synthesis in Plants and Microorganisms; Springer Science and Business Media LLC: New York, NY, USA, 2012; pp. 439–456. [Google Scholar]
- Le Mire, G.; Siah, A.; Brisset, M.-N.; Gaucher, M.; Deleu, M.; Jijakli, M.H. Surfactin Protects Wheat against Zymoseptoria tritici and Activates Both Salicylic Acid- and Jasmonic Acid-Dependent Defense Responses. Agriculture 2018, 8, 11. [Google Scholar] [CrossRef]

| No. | Gene | Code | Primer |
|---|---|---|---|
| 1 | Peroxidase | SsPO-F | TGCTTGGCTTTGACTGGTTC |
| SsPO-R | GCACTCTGCTGGAACATACG | ||
| 2 | Superoxidase distmutase | SsSOD1-F | GAGGTGACTCCAAGGTCTCC |
| SsSOD1-R | GCAGATGTGCAACCGTTAGT | ||
| 3 | Catalase | SsCat1-F | GCTTCTGGTGCTTTCCACAA |
| SsCat1-R | AACCGACAAGCTCAGTACCA | ||
| 4 | Actin | SsActin-F | CAACGATTGAGCGAGGATACA |
| SsActin-R | CGACAAGATGAGGTTGGAAGAG |
| No. | Name | Code | Primer |
|---|---|---|---|
| 1 | Mitogen-activated protein kinase 3 | MPK3-F | CAGGCAACTCCCACAACATC |
| MPK3-R | CTAGTAGGGTCGAGCGTCAA | ||
| 2 | Polyphenol oxidase | PPO-F | CGCCTTACGTTCTTGGGAAT |
| PPO-R | TTGAACCACGGACAGTACCA | ||
| 3 | 3-hydroxy-3-methylglutaryl-coenzyme A reductase | HMGR-F | AGGGCCTTTGTTGCTTGATG |
| HMGR-R | TGTCATGCCATCTCTGAGCA | ||
| 4 | Superoxide dismutase | SOD-F | GGGAGCAATACTACAGTTACTAAT |
| SOD-R | GTTCTACTAATTTAAGCTTTGCCTT | ||
| 5 | Phenylalanine ammonia-lyase | PAL-F | AGCTGAGGCTGTTGACATCT |
| PAL-R | CCTCCAAATGCCTCAAGTCG | ||
| 6 | Glutathione-S-transferase | GST-F | TCCTACACCTGATGTTGTCA |
| GST-R | TCAAACACCTCTTAATTCAATTTGC | ||
| 7 | Actin | ACTIN-F | TGCCATTCTCCGTCTTGACT |
| ACTIN-R | GCTGAGGTGGTGAACGAGTA |
© 2019 by the authors. Licensee MDPI, Basel, Switzerland. This article is an open access article distributed under the terms and conditions of the Creative Commons Attribution (CC BY) license (http://creativecommons.org/licenses/by/4.0/).
Share and Cite
Farzand, A.; Moosa, A.; Zubair, M.; Khan, A.R.; Massawe, V.C.; Tahir, H.A.S.; Sheikh, T.M.M.; Ayaz, M.; Gao, X. Suppression of Sclerotinia sclerotiorum by the Induction of Systemic Resistance and Regulation of Antioxidant Pathways in Tomato Using Fengycin Produced by Bacillus amyloliquefaciens FZB42. Biomolecules 2019, 9, 613. https://doi.org/10.3390/biom9100613
Farzand A, Moosa A, Zubair M, Khan AR, Massawe VC, Tahir HAS, Sheikh TMM, Ayaz M, Gao X. Suppression of Sclerotinia sclerotiorum by the Induction of Systemic Resistance and Regulation of Antioxidant Pathways in Tomato Using Fengycin Produced by Bacillus amyloliquefaciens FZB42. Biomolecules. 2019; 9(10):613. https://doi.org/10.3390/biom9100613
Chicago/Turabian StyleFarzand, Ayaz, Anam Moosa, Muhammad Zubair, Abdur Rashid Khan, Venance Colman Massawe, Hafiz Abdul Samad Tahir, Taha Majid Mahmood Sheikh, Muhammad Ayaz, and Xuewen Gao. 2019. "Suppression of Sclerotinia sclerotiorum by the Induction of Systemic Resistance and Regulation of Antioxidant Pathways in Tomato Using Fengycin Produced by Bacillus amyloliquefaciens FZB42" Biomolecules 9, no. 10: 613. https://doi.org/10.3390/biom9100613
APA StyleFarzand, A., Moosa, A., Zubair, M., Khan, A. R., Massawe, V. C., Tahir, H. A. S., Sheikh, T. M. M., Ayaz, M., & Gao, X. (2019). Suppression of Sclerotinia sclerotiorum by the Induction of Systemic Resistance and Regulation of Antioxidant Pathways in Tomato Using Fengycin Produced by Bacillus amyloliquefaciens FZB42. Biomolecules, 9(10), 613. https://doi.org/10.3390/biom9100613

